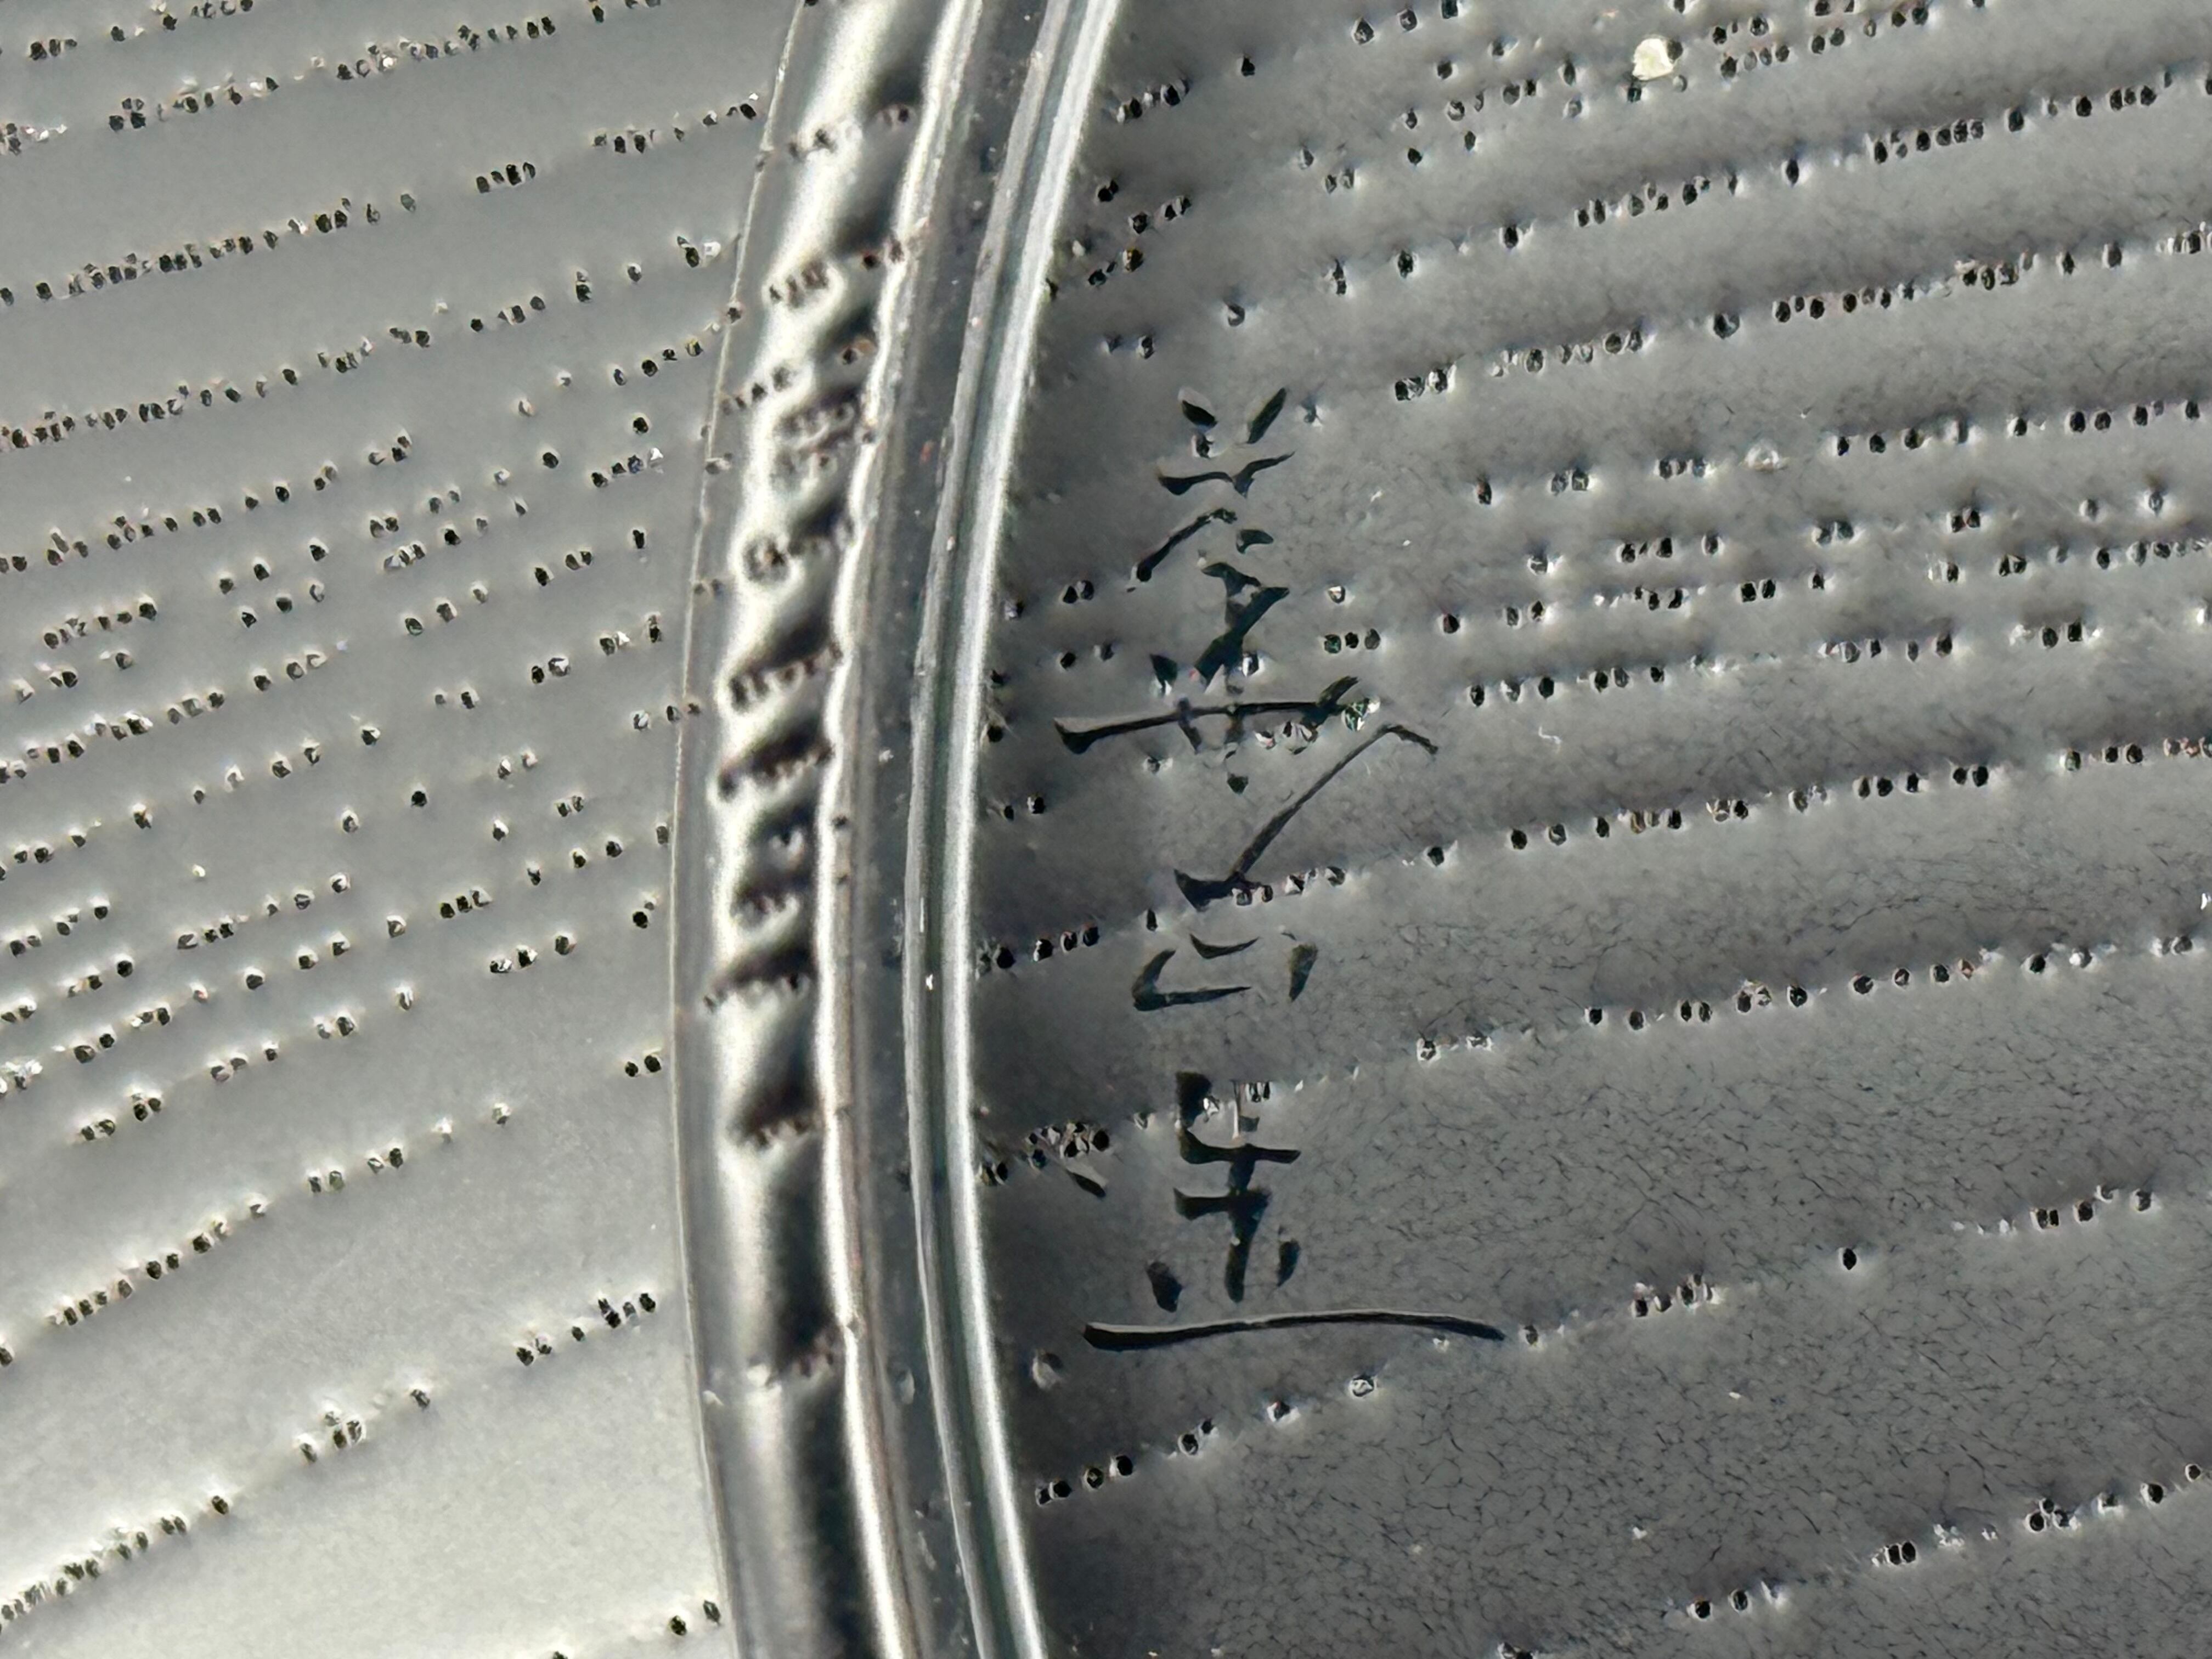

1/13
吉田華正 即中斎好写 独楽形 平食篭 共箱 保証品 茶道具 食篭 食籠
¥40,000
残り1点
International shipping available
商品説明+++
高さ 約10センチ 口径 約24センチ
多少の使用感はありますが、綺麗な状態です
本物保障
○お客様からご連絡を頂いた後、お振込金額を折り返しご案内差し上げます。
○ご連絡が多少遅れることがございますがご理解の程宜しくお願いいたします。
●注意事項●
○振込手数料はお客様のご負担になりますのでご了承ください。
○あくまで中古品になりますので、神経質な方は、ご入札をお控えください。
○基本的には返品不可ですが、明らかに記載していないニューや直しなどの傷があった場合、
責任は当方にありますので商品到着後一週間までキャンセル受付可能です。代金及び送料は 全額御返金致します。御安心の上御入札下さい。
○写真により色など実物と多少誤差が生じる場合があることを予めご了承くだい。
○土、日曜日、祝日は対応が遅れることがございます。ご了承ください。
-
レビュー
(0)
最近チェックした商品
同じカテゴリの商品
その他の商品